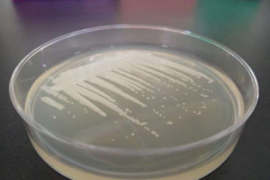

関連記事
光合成を行わない「白い緑藻」プロトテカの進化の謎 筑波大学の研究
寒天培地上でコロニーを形成するプロトテカ(Prototheca cutis JCM 15793)。(画像:筑波大学発表資料より)[写真拡大]
プロトテカという緑藻がいる。緑藻なのだが、色は白い。つまり、広義の分類学上の位置付けで緑色植物門(緑藻)に含まれるのだが、葉緑素を持たず、光合成も行わず、色が白いのである。その性質からいわゆる、従属栄養生物の一種にも数えられる。その遺伝的性質に関する研究を、筑波大学が行った。
【こちらも】光合成をしない新種の植物「オモトソウ」石垣島で発見
プロトテカは病気の原因にもなる。プロトテカ症と言い、人獣共通感染症であるので、主には獣医学の世界で研究されている。
単細胞生物であり、顕微観察するとその細胞は2~15ナノメートルほどのサイズのいびつな球形をしており、酵母にも似ていて、菌類と間違えられることも多々ある。特に寒天培地で培養した時の姿は白いコロニーなので酵母とそっくりである。
プロトテカの近縁種に、有名なクロレラがいる。クロレラは緑色であり、光合成をする。従属栄養生物は謎の多い研究分野であるので全てがそうと決まったわけではないが、プロトテカの祖先はもともと光合成を行っていたと考えられている。ちなみに、やはり光合成の能力を持っていたが喪失したと考えられる生物として、ほかにラフレシアやマラリア原虫がいる。
光合成は強力な栄養獲得手段である。それを、なぜわざわざ放棄する方向に彼らは進化したのか。その謎に迫ったのが今回の研究だ。
調べたところ、光合成の能力は一度の変異で失われたわけではなく、3回、つまり三段階に渡って段階的に喪失されたらしい。このことは、プロトテカのようなもともと栄養獲得手段を複数持っていた種類の存在にとって、光合成能力を喪失するということはさほど重要な意味を持たないのではないか、という示唆を与えるものである。
なお、研究の詳細は、「無色の緑藻プロトテカにおける、複数回の光合成能の喪失と収斂的なゲノムの縮小」の日本語題のもと、Scientific Reportsに掲載されている。(記事:藤沢文太・記事一覧を見る)
スポンサードリンク
